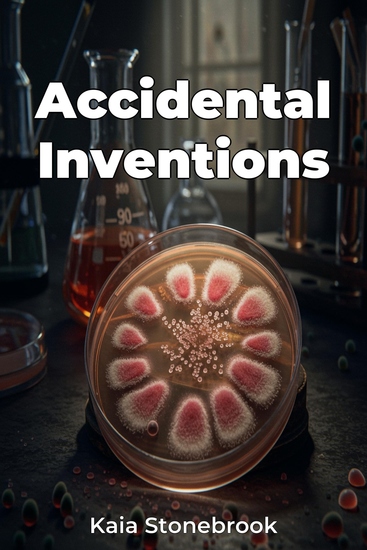

Accidental Inventions
Kaia Stonebrook
Traducteur A AI
Maison d'édition: Publifye
Synopsis
Accidental Inventions explores the fascinating history of unintended discoveries and their profound impact on our world.From medical marvels like the accidental creation of penicillin, born from a contaminated petri dish, to culinary accidents that gave rise to corn flakes and potato chips, the book reveals how chance encounters and unforeseen errors have shaped scientific progress and industrial innovations. It underscores that many significant breakthroughs arose not from deliberate planning, but from serendipity in science.The book delves into the scientific principles, historical context, and human element behind these chance discoveries, highlighting the importance of curiosity and open-mindedness. Examining how observation and insight transformed accidents into innovations, the book progresses through sections detailing culinary mishaps, medical breakthroughs, and industrial innovations.By providing a comprehensive view of how these discoveries come about, Accidental Inventions encourages readers to embrace the unexpected and cultivate a mindset conducive to innovation.














